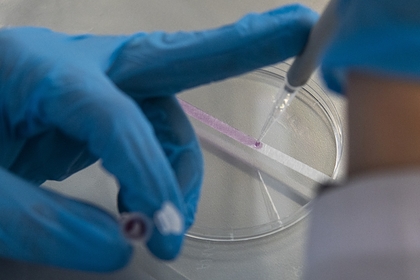
Российские ученые разработали тест для диагностики рака по выдыхаемому воздуху

Российские ученые разработали тест для диагностики рака по выдыхаемому воздуху
Российские ученые разработали тест для диагностики рака по выдыхаемому воздуху
Российские ученые разработали импортозамещающую тест-систему для диагностики рака органов пищеварения по анализу выдыхаемого пациентом воздуха. Об этом сообщается на сайте закупок госкорпорации «Росатом».
На разработку технологии и организацию производства потратят 4,5 миллиона рублей.
Ученые предлагают начать производство разработанной ими системы, которая, согласно опубликованным материалам, позволяет эффективно диагностировать рак. Тесты обладают преимуществами по сравнению с существующей зарубежной техникой. Специалисты «Радиевого института имени Хлопина» в Санкт-Петербурге должны подготовить техническое задание на организацию производства.
Система позволит на ранних стадиях диагностировать злокачественные заболевания органов пищеварения и оценивать эффективность проведенного лечения. Эта диагностика основана на анализе соотношения между изотопами углерод-13 и углерод-12, которые содержатся в выдыхаемом пациентом воздухе.
«Такой диагностический комплекс сократит затраты на приобретение импортного оборудования и расходных материалов, а главным образом повысит охват населения ранней диагностикой наиболее распространенных болезней органов пищеварения, что существенно повысит продолжительность и качество жизни населения», — отмечается в техзадании.
Сейчас в России используются зарубежные тест-системы. Отмечается, что их количества недостаточно для диагностики широко распространенных болезней органов пищеварения.
Источник: https://lenta.ru/
